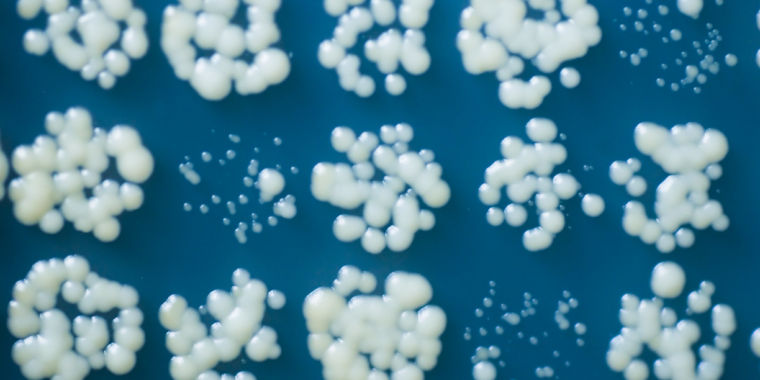

Brewing fuel —
Systems-level engineering of a living thing is remarkably complicated.

Enlarge / Colonies of genetically modified yeast.
A little while ago, we covered the idea of using photovoltaic materials to drive enzymatic reactions in order to produce specific chemicals. The concept is being considered mostly because doing the same reaction in a cell is often horribly inefficient because everything else in the cell is trying to regulate the enzymes, trying to use the products, trying to convert the byproducts into something toxic, or up to something even more annoying. But in many cases, these reactions rely on chemicals that are only made by cells, leaving some researchers to suspect it still might be easier to use living things in the end.
A new paper in Nature Catalysis may support or contradict this argument, depending on your perspective. In the end, the authors of the new paper re-engineer standard brewer’s yeast to produce molecules that can be used as fuel for internal combustion engines. The full catalog of changes they have to make is a bit mind-numbing and most achieve a small, incremental increase in production. The end result is a large step forward toward biofuel production, but the effort involved is intimidating.
Making fuel
Brewer’s yeast, as the name implies, can already produce a biofuel: alcohol. But ethanol isn’t a drop-in replacement for many current uses, which raises questions about its overall utility. If we have to re-engineer both our engines and our infrastructure in order to use it to replace fossil fuels, then there’s not much space for a smooth transition away from gasoline and other liquid fuels.
But yeast obviously produce a lot of chemicals in addition to ethanol, and some of them are much more similar to our hydrocarbon fuels. Most liquid fuels are short strings of carbon atoms with hydrogen linked to each carbon. That mostly describes the building blocks of fats, which differ from hydrocarbon fuels in that one of the carbon atoms at the end of the string is hooked up to a couple of oxygens. These molecules also have a longer string of carbon atoms than a typical fuel—18-24 carbon atoms, rather than six to 12. But living things produce them in abundance, since they’re used to make membranes and store energy.
Still, as challenge go, this one sounds relatively simple: get the cell to make shorter versions of what it’s already making, then eject those into the media the cells are growing in. We can simply harvest the media, separate out the fuel molecules, and then let the yeast start afresh.
It’s not at all easy.
To begin with, making these molecules is very energy-intensive (they work as energy storage after all), so the cell regulates how much of them are made. Adding to the challenge, the shorter versions of these fat materials turn out to be toxic to the cells, and we’re not entirely sure why. Finally, they’re not especially soluble in the water that the yeast live in. All of which means it’s not at all easy to get this to work, but an international team of researchers was determined to try.
Re-engineering
It’s worth stepping back and taking a look at how the cell normally makes these molecules. Most organisms have two sets of enzymes to do the job. In one case, the enzymes all act separately. In another, the enzymes are all complexed in a single unit, which makes the pathway more efficient. The activity of the pathway is tightly regulated in terms of how many of these enzymes are made, how active the enzymes are, and how much of the raw materials they use are available.
The actual hydrocarbons are built up in stages. The process starts with an extremely short hydrocarbon chemically tethered to a molecule that’s recognized by the enzymes involved. Enzymes add additional carbon atoms to the growing chain in pairs, gradually extending it. As the chain gets progressively longer, its ability to fit into the active site of the enzymes gradually gets worse. At random points in the process, a separate enzyme can cut the hydrocarbon’s tether off, terminating the process. This typically happens when the chains are between 16 and 22 carbons long.
Obviously, there are a number of places to intervene in this process in order to favor the production of shorter chains. The research team appears to have decided to try all of them.
To begin with, there’s the issue of regulation. Since the researchers were working in yeast, they started with a bacterial enzyme complex. Since the enzymes are from a completely unrelated organism, they should be unable to interact with any factors that normally slow down the enzymes’ activity. The genes encoding these enzymes were placed in a DNA construct that ensured they were produced at high level. All of these changes should ensure that there’s always a high level of activity along the pathway that will be producing fuel molecules, provided the raw materials are plentiful.
To be cautious there, the research team then engineered the yeast to produce more of the raw materials. Just in case.
Not done yet
Then there’s an issue of carbon-chain length, more specifically the need to keep the chains relatively short. Other research groups have identified a series of mutations that ensure that longer carbon chains don’t fit in the key enzymes as well. So those were engineered into the system. Then, the authors merged in extra copies of a gene that cuts the growing chain from its tether, stopping the elongation process. This version of the gene was engineered to be part of the complex that extends the chain, ensuring that it could easily interact with the growing chains before they got too long.
Combined, all these changes should produce more short-chain hydrocarbons in the yeast cell. And they do—but not a lot more. This wasn’t a surprise because, as noted above, these molecules are toxic to the cell. Since we don’t understand why, there was no way of directly engineering tolerance to them. Instead, the researchers simply grew yeast strains in high levels of short-chain molecules for multiple generation, allowing evolution to select one that tolerated them better. The researchers sequenced the genomes of multiple evolved strains and identified two key mutations.
Separately, they started with a protein that yeast use to pump toxins outside the cell, and sent that through two rounds of mutation and selection, looking for looking for version that more efficiently ejected the hydrocarbon molecules they were producing. The results of the two separate bits of directed evolution were combined in the yeast strain being used. Production went up a bit more.
Of course, from the cell’s perspective, all these short hydrocarbons floating around are mistakes—biochemical dead ends. So it’s not a surprise that cells also have enzymes that re-attach them to the linker that allows the synthesis enzymes to re-engage with them. These enzymes had to be deleted as well, allowing the levels of production to climb a bit more.
Protect the hydrocarbons
Finally, at this point, with the entire yeast metabolism re-engineered, there was one more hurdle. The build-up of the desired hydrocarbons in the growth media ended up being high enough that the cells started getting sick. So, the researchers figured out they could add a layer of an organic solvent on top of the water the yeast were growing in and the hydrocarbons would end up in that. This would keep them safely away from the yeast.
No single change was decisive in increasing the yield of the desired chemicals. But with each change, the yield went up a bit, and many of the changes had a synergistic effect on the output. The yeast started out by producing these chemicals in quantities measured in milligrams per liter of cultured yeast. By the end, the researchers were looking at grams.
Yeast are probably still better at producing ethanol efficiently than they are at making these hydrocarbon molecules. But, as the authors note, these materials are much more useful as fuels and as starting materials for other chemicals. As a result, they’re much more valuable. Given all the work involved in just making them, however, the authors can be forgiven for not doing a full economic analysis of whether these yeast actually make economic sense as they currently stand or whether even more work might be needed.
Nature Catalysis, 2019. DOI: 10.1038/s41929-019-0409-1 (About DOIs).